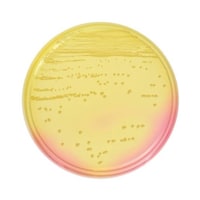
日本ベクトン・ディッキンソン BD BBL(TM) マンニット食塩寒天培地 20枚

カゴメ トマトジュース 食塩無添加スマートペット x15個
低カロリー、リコピンたっぷり食塩・着色料・保存料は使用しておりません
低カロリー、リコピンたっぷり食塩・着色料・保存料は使用しておりません+もっと見る
茂野製麺 味川柳うどん食塩無添加 4973351300302 5袋(270g×5袋)
食塩無添加だから鍋物にお好みの長さに折って入れるだけ。
食塩無添加だから鍋物にお好みの長さに折って入れるだけ。+もっと見る
茂野製麺 味川柳そうめん食塩無添加 4973351200145 5袋(270g×5袋)
食塩無添加だから鍋物煮麺にお好みの長さに折って入れるだけ。
食塩無添加だから鍋物煮麺にお好みの長さに折って入れるだけ。+もっと見る
いなば食品 北海道食塩無添加ミックスビーンズ50g 40個 245190 缶詰・瓶詰(野菜・フルーツ類) 1ケース(50g・40個入)
北海道産豆100%使用。食塩無添加です。
北海道産豆100%使用。食塩無添加です。+もっと見る
いなば食品 ライトツナ食塩・オイル無添加 70g 884894 缶詰・瓶詰(ツナ・魚介類) 1ケース(3個入×16)
ノンオイル・食塩無添加のヘルシーなツナです。
ノンオイル・食塩無添加のヘルシーなツナです。+もっと見る
食塩濃度計 EA776BY28 水質検査・測定用品 1個
食塩濃度0.0から28.0%を測定、自動温度補正付き。約110gの軽量コンパクト設計。
食塩濃度0.0から28.0%を測定、自動温度補正付き。約110gの軽量コンパクト設計。+もっと見る
日本ベクトン・ディッキンソン BD BBL(TM) マンニット食塩寒天培地 20枚
マンニット食塩寒天培地は、Staphylococcus、とくに黄色ブドウ球菌の選択分離に用いられます
マンニット食塩寒天培地は、Staphylococcus、とくに黄色ブドウ球菌の選択分離に用いられます+もっと見る
大塚食品 あいこちゃん青の鯖 食塩不使用 150gx24 4953009114291 缶詰・瓶詰(ツナ・魚介類) 1箱(24個入)
国内で漁獲された鯖を食塩を使わず、水のみで調理しました。食塩を使っていない為、塩分の摂取を控えている方でも気にせずお召し上がりいただけます。
国内で漁獲された鯖を食塩を使わず、水のみで調理しました。食塩を使っていない為、塩分の摂取を控えている方でも気にせずお召し上がりいただけます。+もっと見る
湖池屋 湖池屋 プライドポテト GOLD STYLE 幸せ極みだし食塩不使用 36gx14
まるで塩を使っているかのような美味しさの食塩不使用ポテトチップス。5種の食材の旨みと焙煎唐辛子のキレでじゃがいも本来の美味しさを引き出しました。食塩不使用とは思えない満足感のある幸せな味わいです。
まるで塩を使っているかのような美味しさの食塩不使用ポテトチップス。5種の食材の旨みと焙煎唐辛子のキレでじゃがいも本来の美味しさを引き出しました。食塩不使用とは思えない満足感のある幸せな味わいです。+もっと見る
いなば食品 食塩無添加ヤングコーン 120g 40個 245251 缶詰・瓶詰(野菜・フルーツ類) 1ケース(120g・40個入)
食塩無添加なので自分好みの味付けができます。
食塩無添加なので自分好みの味付けができます。+もっと見る
いなば食品 ライトツナ食塩無添加(70g×5缶)×16個 884917 缶詰・瓶詰(ツナ・魚介類) 1ケース(70g×5缶×16個)
ノンオイル・食塩無添加のヘルシーなツナです。
ノンオイル・食塩無添加のヘルシーなツナです。+もっと見る
伊藤食品 あいこちゃんツナまぐろ水煮食塩不使用 3缶×12 4953009113805 缶詰・瓶詰(ツナ・魚介類) 1セット(3缶入×12)
ツナ水煮缶詰を食塩を使わず、野菜スープのみで味付けました。食塩を気にされる方、離乳食などにご利用いただけます。容量は70gで食べきりサイズとし、開けやすいプルトップ構造となっています。
ツナ水煮缶詰を食塩を使わず、野菜スープのみで味付けました。食塩を気にされる方、離乳食などにご利用いただけます。容量は70gで食べきりサイズとし、開けやすいプルトップ構造となっています。+もっと見る
いなば食品 ライトツナ食塩無添加タイ産(70g×3缶)×15個 685033 缶詰・瓶詰(ツナ・魚介類) 1ケース(70g×3缶×15個)
ノンオイル・食塩無添加のヘルシーなツナです。
ノンオイル・食塩無添加のヘルシーなツナです。+もっと見る
デルモンテ 食塩無添加 野菜ジュース 800ml ×15 4902204003770 1セット(800ml×15個)
世界中から厳選した完熟トマトなど21種類の野菜をブレンド。食塩無添加の野菜ジュースです。セロリの風味が特長のすっきりとした味わいです。
世界中から厳選した完熟トマトなど21種類の野菜をブレンド。食塩無添加の野菜ジュースです。セロリの風味が特長のすっきりとした味わいです。+もっと見る
いなば食品 とりささみ食塩無添加(70g×3缶)×15個 568053 缶詰・瓶詰(肉類) 1ケース(70g×3缶×15個)
高たんぱく・低脂肪・低カロリー。食塩無添加なので自分好みの味付けができます。
高たんぱく・低脂肪・低カロリー。食塩無添加なので自分好みの味付けができます。+もっと見る
デルモンテ 食塩無添加 トマトジュース 800ml ×15 4902204003701 野菜ジュース 1セット(800ml×15個)
世界中から厳選した完熟トマトをブレンド。食塩無添加の100%トマトジュース(濃縮還元)です。トマトの味わいが濃厚だから、割り材にもご使用いただけます。
世界中から厳選した完熟トマトをブレンド。食塩無添加の100%トマトジュース(濃縮還元)です。トマトの味わいが濃厚だから、割り材にもご使用いただけます。+もっと見る
日本ベクトン・ディッキンソン BD BBL(TM) 卵黄加マンニット食塩寒天培地 20枚
卵黄加マンニット食塩寒天培地は臨床材料、食品等から黄色ブドウ球菌の選択分離および生菌数の検査に用いられます
卵黄加マンニット食塩寒天培地は臨床材料、食品等から黄色ブドウ球菌の選択分離および生菌数の検査に用いられます+もっと見る
キッコーマン 減塩しょうゆ 750ml x6 4901515123184 醤油 1セット(750mlx6)
本醸造しょうゆのおいしさ、華やかな香りはそのままに、食塩分を40%カットした減塩しょうゆです。食塩分に気をつけている方だけでなく、健康的な食生活を心がけている方にもお勧めします。
本醸造しょうゆのおいしさ、華やかな香りはそのままに、食塩分を40%カットした減塩しょうゆです。食塩分に気をつけている方だけでなく、健康的な食生活を心がけている方にもお勧めします。+もっと見る
ADVANTEC ソルセイブ 研究用 1組(10個)
減塩の参考として、塩からさを簡単に比較確認するための濾紙です。食塩含有量の異なる濾紙を舌に乗せ、どの食塩含有量の濾紙を塩からく感じるかにより、塩からさを比較確認します。
減塩の参考として、塩からさを簡単に比較確認するための濾紙です。食塩含有量の異なる濾紙を舌に乗せ、どの食塩含有量の濾紙を塩からく感じるかにより、塩からさを比較確認します。+もっと見る
キッコーマン 特選丸大豆 減塩 750ml x6 4901515123191 醤油 1セット(750mlx6)
丸大豆のうまみを丸ごと引き出した特選丸大豆しょうゆから、おいしさ、香りはそのままに、食塩分だけを40%減らしました。食塩分に気をつけている方だけでなく、健康的な食生活を心がけている方にもお勧めします。
丸大豆のうまみを丸ごと引き出した特選丸大豆しょうゆから、おいしさ、香りはそのままに、食塩分だけを40%減らしました。食塩分に気をつけている方だけでなく、健康的な食生活を心がけている方にもお勧めします。+もっと見る
キッコーマン 新鮮特選丸大豆減塩しょうゆ 450ml x12 4901515121661 醤油 1セット(450mlx12)
丸大豆のうまみを丸ごと引き出した特選丸大豆しょうゆから、おいしさ、香りはそのままに、食塩分だけを50%減らしました。食塩分に気をつけている方だけでなく、健康的な食生活を心がけている方にもお勧めします。
丸大豆のうまみを丸ごと引き出した特選丸大豆しょうゆから、おいしさ、香りはそのままに、食塩分だけを50%減らしました。食塩分に気をつけている方だけでなく、健康的な食生活を心がけている方にもお勧めします。+もっと見る
ハンナ デジタル塩分計
+もっと見る
伊藤食品 あいこちゃん鰯水煮食塩不使用190gx24 4953009113928 缶詰・瓶詰(ツナ・魚介類) 1箱(24個入)
脂の乗った国産のいわしを、食塩を一切使用せず水煮に仕上げました。いわし本来のうま味をご堪能頂けます。そのままでももちろん、素材缶としてさまざまな料理にもお使い頂けます。化学調味料不使用です。
脂の乗った国産のいわしを、食塩を一切使用せず水煮に仕上げました。いわし本来のうま味をご堪能頂けます。そのままでももちろん、素材缶としてさまざまな料理にもお使い頂けます。化学調味料不使用です。+もっと見る
チェスコ 【冷蔵】チェスコ チーズonクラッカー 20枚
サクサクの食感で、チーズによく合うクラッカーです。食塩無添加でチーズの味を引き出します。
サクサクの食感で、チーズによく合うクラッカーです。食塩無添加でチーズの味を引き出します。+もっと見る
アライドコーポレー アライドコーポレーション フィッシュソース ナンプラー
タイ国内で最も有名なブランドの一つ。熟成期間12ヶ月。バランスブランドと比べ食塩の配合率が高く低コストなナンプラーです。
タイ国内で最も有名なブランドの一つ。熟成期間12ヶ月。バランスブランドと比べ食塩の配合率が高く低コストなナンプラーです。+もっと見る
東洋ナッツ 食塩無添加 クルミ 95g x10個
ハイブリッド蒸気ロースト製法でクルミ独特の渋みを抑え、ふっくらと軽い食感に仕上げました。
ハイブリッド蒸気ロースト製法でクルミ独特の渋みを抑え、ふっくらと軽い食感に仕上げました。+もっと見る
山本かじの 元祖十割そば 200g 20個 101010 1セット(200g×20)
原材料そば粉100%の十割そば。食塩無添加でそば湯も取れる元祖の味。
原材料そば粉100%の十割そば。食塩無添加でそば湯も取れる元祖の味。+もっと見る
カネタ・ツーワン こだわりゲンさんカット味あし 10g 4902046958207 おつまみ・珍味 1箱(12個入)
いかの足を食塩と唐辛子等でピリ辛に香ばしく仕上げました。
いかの足を食塩と唐辛子等でピリ辛に香ばしく仕上げました。+もっと見る
アスベル 2151フォルマHG フタ付食塩入れ 03620501 食器・卓上用品(その他) 1個
ステンレストップ&ガラス製本体の、上質感あふれるシリーズです。開閉しやすいワンタッチフタ!
ステンレストップ&ガラス製本体の、上質感あふれるシリーズです。開閉しやすいワンタッチフタ!+もっと見る